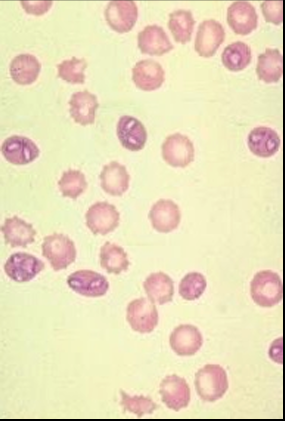
<p>What does this image show?</p>

1/138
Looks like no tags are added yet.
Name | Mastery | Learn | Test | Matching | Spaced | Call with Kai |
|---|
No study sessions yet.
What are protozoa?
single-celled
eukaryotes
definitive host
one in which a parasite reaches maturity and usually reproduces sexually
Intermediate host
one in which the parasite develops, but does not reach maturity or reproduce sexually

vector
intermediate host that carries and transmits parasite developmental stages to another host
Name an example of a protozoa that has a direct life cycle
cryptosporidium
Name an example of a protozoa that has an indirect life cycle
toxoplasma
What are the 3 categories of protozoan lifecycles?
direct
indirect
vector-borne
What are the 3 arthropod-borne protozoa of major importance in humans?
plasmodium (malaria)
trypanosoma (trypnosomiasis)
leishmania (leishmaniasis)
What are the arthropod-borne protozoa of major importance in animals?
trypanosoma
theileria (theileriosis)
babesia (babesiosis)
plasmodium (avian malaria)
leishmania
What vectors are protozoa/parasites commonly transmitted via?
fly
tick
What are the groups of flies that are vectors for protozoa?
flagellates
apicomplexa
Which group of ticks are vectors for protozoa?
apicomplexa
Which group of ticks are vectors for bacteria?
rickettsiales
What types of flies are flagellates?
tsetse flies
biting flies
sand flies
What type of flies are apicomplexa?
mosquitoes
What parasites do tsetse flies and biting flies carry?
trypanosoma
What parasite do sand flies carry?
leishmania
What parasite do mosquitoes carry?
plasmodium
What disease does trypanosoma cause?
trypanosomiasis
What disease does Leishmania cause?
leishmaniasis
What disease does plasmodium cause?
malaria
What parasites do apicomplexa ticks carry?
babesia
Theileria
What bacteria do rickettsiales carry?
Ehrlichia
Anaplasma
What disease does babesia cause?
babesiosis
What disease does Theileria cause?
Theileriosis
What disease does Ehrlichia cause?
ehrlichiosis
What disease does anaplasma cause?
anaplasmosis
What’s the basic tick life-cycle?
eggs in engorged female
larva
nymph
adult
What percentage of a ticks life-cycle do they spend on host?
25%

What does this image show?
basic tick life-cycle

What does this image show?
tick egg mass

What does this image show?
tick larva

What does this image show?
tick nymph

What does this image show?
tick adult

What does this image show?
one-host tick lifecycle

Name an example of a one-host tick
rhipicephalus (boophilus) microplus

What is rhipicephalus (boophilus) microplus?
important tropical cattle tick

What does this image show?
two-host tick lifecycle

Name an example of a two-host tick
hyalomma sp.

What is Hyalomma sp.?
important Mediterranean and subtropical livestock tick

What does this image show?
three-host tick lifecycle
Name an example of a three-host tick
ixodes ricinus
What is ixodes ricinus?
familiar UK sheep tick
What are the 2 types of transmission?
transstadial
transovarial
What is transstadial transmission?
can only transmit disease in one generation of lifecycle
What is transovarial transmission?
can transmit disease through multiple generations (from parent to offspring)
List 3 important European Tick Species
Ixodes ricinus
Rhipicephalus sanguineus
Dermacentor reticulatus
Which tick species is most prevalent in the UK?
Ixodes ricinus
What cell is babesia a parasite of?
red blood cells
What type of transmission is Babesia transmitted by?
transovarial transmission
What is the main Babesia species in Europe?
Babesia canis
What is Babesia canis transmitted by?
Dermacentor reticulatis
List the 4 canine babesia species that are important in Europe
babesia (canis) canis
babesia (canis) vogeli
babesia gibsoni
babesia vulpes
Where is babesia (canis) vogeli found?
mediterranean
Where is babesia gibsoni found?
sporadically reported in Europe
Where is Babesia vulpes found?
endemic in northern Spain

What does this image show?
annual incidence of canine babesiosis in Europe

What does this image show?
2017 distribution of Rhipicephalus sanguineus
blue line = previous distribution
What is the pathogenesis of canine babesiosis?
rapid division of parasite in erythrocytes
haemolytic anaemia
splenomegaly
What are the clinical signs of canine babesiosis?
acute disease
1-2 weeks post tick-feeding
fever
anaemia
haemoglobinuria (‘redwater’)
jaundice
neurological signs
How do you treat canine babesiosis?
antiprotozoal drugs
blood transfusion
How can you diagnose babesia spp.?
blood smear (Giemsa stain)
PCR
What does this image show?
babesia spp.

What is shown on the left and right of this image?
left = babesia divergens
right = babesia major
What is the size of babesia divergens?
small
What is the size of babesia major?
large
What is the vector of babesia divergens?
ixodes ricinus
What is the vector of babesia major?
haemaphysalis punctata (red sheep tick)
What is the distribution of babesia divergens?
all areas with ixodes ricinus
What is the distribution of babesia major?
S.E. England
Where is babesia divergens important?
in endemic areas
Is babesia major important?
minor importance
What is the vertebrate host of Babesia divergens?
cattle
What is the disease that babesia divergens causes called?
redwater fever
What are the clinical signs of babesia divergens in cattle?
pyrexia, anorexia, depression
anaemia, haemoglobinuria, icterus
diarrhoea or constipation
occasionally neurological signs
How can you distinguish haemoglobinuria from haematuria?
RBC settle on standing in haematuria
What factors affect the epidemiology of bovine babesiosis in the UK?
restricted to pastures that support high numbers of ticks
disease outbreaks associated with peaks of tick feeding activity
principally a disease of older animals
inverse age resistance
enzootic stability develops in endemic areas
What is enzootic stability?
high levels of challenge, but low disease levels
What is inverse age resistance (like seen in bovine babesiosis)?
calves up to 6 months protected (colostral immunity in endemic areas & innate resistance)
infected cattle develop non-sterile immunity - immunity prevents further infection
What are the risk factors for outbreaks of bovine babesiosis?
introduction of babesia naiive adults to tick areas
introduction of tick-infested cattle to naiive herds
fluctuations in tick numbers
Why might there be fluctuations in tick numbers?
land use changes
changes in pasture harvesting
presence in dipped sheep
use of endectocides for helminths
perturbation of ‘enzootic stability’
What can be put in place to control bovine babesiosis?
ensure adequate exposure of young animals to ticks before 6 months of age
treat affected animals
monitor introduced adult cattle for evidence of ifection
tick reduction measures (e.g. dipping - not UK)
vaccination (not in UK)
Is Leishmania present in the UK?
NO
What are the vertebrate hosts of Leishmania?
human
dog
wild animals
Where is Leishmania found?
Mediterranean basin
Africa
Asia
Central and South America
What is the vector of Leishmania?
bloodsucking phlebotomine sandfly
What cells of the body does Leishmania infect?
macrophages
What are 2 main forms of Leishmania?
visceral (humans and dogs)
cutaneous (humans)
(and mucocutaneous form in humans)
Is Leishmania a zoonosis?
YES
What species of Leishmania is most common in Europe?
Leishmania infantum
Why is canine leishmaniasis a potential problem in the UK?
dogs important from southern and eastern europe
stray dogs brought into UK from endemic countries
What is the incubation period of canine leishmaniasis?
months to years
What are the clinical signs of canine leishmaniasis?
skin lesions
ocular abnormalities
epistaxis
weight loss
lethargy

What does this image show?
canine visceral leishmaniasis
Summarise the pathology of canine leishmaniasis
anaemia
thrombocytopenia
hyperglobulinemia
How can you diagnose canine leishmaniasis?
cytology on Giemsa-stained lymph node or bone marrow aspirates
PCR
serology
How can you treat canine leishmaniasis?
pentavalent antimonials (toxicity) - traditional
allopurinol
miltefosine (safer, expensive) - newer
Even if treated, what may happen to dogs suffering from canine leishmaniasis?
remain carriers
may relapse
may remain infectious to sand flies
How can you prevent getting infected with canine leishmaniasis if taking a dog abroad?
insecticides - topical or impregnated collars
imidacloprid, deltamethrin
What issues does trypanosomiasis cause?
anaemia and loss of production in animals
fatal in humans
‘sleeping sickness’